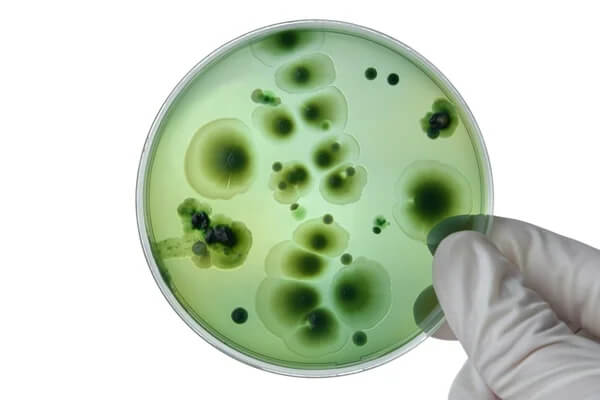

99% Purity Research Grade Peptides for Sale
Peptide Works, the premier source for research peptides. Backed with world wide shipping, rest assured we will deliver the highest quality, research-grade products to your door-step at realistic price.
Buy high quality peptides online on the internet right now!


Our capsules proudly contain the high purity bioactive peptides sourced for research purposes.

Our powerful, high quality nasal sprays deliver just one accurate dose.

Our easy-to-use pen can be carried anywhere and filled out anytime.

Our high quality peptide vials are able to be shipped internationally and stored for months at a time.
Most Wanted
Top Selling Products

High Quality Peptides for all researchers At Peptide Works we supply premium grade, high quality research peptides. All of our products are meticulously formulated and made in cGMP-certified facilities. Our stringent quality control process allows us to guarantee our peptides to be of the highest purity, offering you reliable and consistent results for your research. We have a focus on promoting value for money by way of providing similar pricing, yet excellent quality products. In addition to our premium quality leather goods, we provide excellent customer service so you get the attention and information you need.
Why Peptide Works?
Peptide Works is proud to offer incredible support and service to our customers.
We are quick and inexpensive and continue to add new packages to save the researcher money.
We ensure that peptides are of a minimum purity of +99%; or complex peptide is +98%.
Fast and efficient dispatch to most countries across the globe. We have among the best international standing rates and we strive to get your order to you on time.
Expert Advice

The GI tract motility has been one of the popular research themes because it is closely related to digestion and gut functions.
When
Fungal infections can be recalcitrant, outlasting typical treatments and debilitating the body’s protections. Recently, however, researchers have begun to.

Ever wonder how your body starts to heal itself after an injury, or stress? Researchers are asking the?
same"